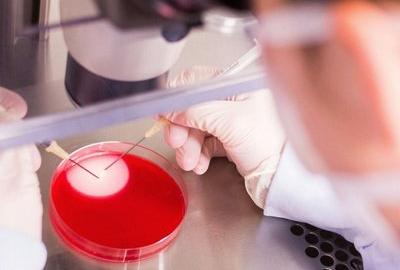
Exigences  GBEA

--- Nos Offres Q-HSE ---
Diagnostics
Accompagnement
Consultance
Training & Certification
Intégration migration et système management
---
ISO 13485 ---

Exigences ISO 13485

Exigences ISO 9001

Audit interne
--- ISO 15189 ---

Exigences ISO 15189

Exigences
GBEA

Audit interne
---
GBEA
---
Exigences
GBEA

Exigences ISO 15189

